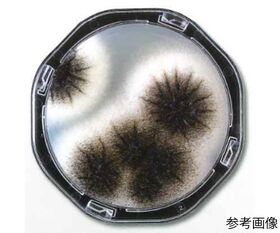

説明
【特徴】
●器具・培地調整等の事前準備が不要で、1人で容易に操作できます。
●汚染実態の把握・消毒殺菌効果判定が肉眼ででき、また汚染源の特定菌の有無を判定することができます。
●培地を凸状に盛り上げた、コンタクト(接触)平板です。
【仕様】
●使用目的:食品真菌用
●培地色調:白
●測定する集落:発育した真菌の集落
●入数:1箱(10枚/袋×4袋入)
●培地表面積:約25cm2
●※保存方法2~10℃(遮光・凍結不可)
●※有効期限:製造より6ヶ月
追加情報
メーカー名:
栄研化学
メーカー品番:
PK0007
予定納期:
注文から1~3日で発送